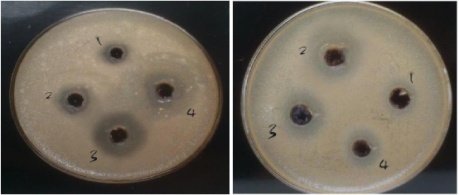

1Department of pharmaceutical Sciences, Mahatma Gandhi university, Cheruvandoor campus, 2Department of pharmaceutical Sciences, RIMSR, rubber board P. O, Mahatma Gandhi university, Kottayam.
Email: akhilamadathil@yahoo.com
Received: 14 Aug 2014 Revised and Accepted: 15 Sep 2014
ABSTRACT
Objective: Infectious diseases are a leading cause of global disease burden with high morbidity and mortality especially in the developing world. Furthermore, there have been threats of new diseases during the past three decades due to the evolution and adaptation of microbes and the re-emergence of old diseases due to the development of antimicrobial resistance and the capacity to spread to new geographic areas. Since antiquity, humans have used plants to treat common infectious diseases and some of these traditional medicines are still included as part of the habitual treatment of various maladies. Objective of the study was to evaluate, one of the traditionally used drugs, Marselia minuta for its antimicrobial activity.
Methods: Extracts of M. minuta was prepared using successive solvent extraction method and the antibacterial activity of thus prepared petroleum ether, chloroform, ethyl acetate, alcohol and aqueous extracts of M. minuta was performed using agar well diffusion method. Four bacterial strains were used to assess the antimicrobial properties of the plant extracts viz Escherichia coli, Streptococcus pneumonia, Pseudomonas aeruginosa and Staphylococcus aureus.
Results: All the extracts showed activity towards the tested microorganisms except petroleum ether extract. Ethyl acetate extract was more active towards S. aureus and P. aeruginosa. Alcohol and chloroform extract was active toward E. coli and P. aeruginosa. Aqueous extract was active against E. coli and S. aureus. minimum inhibitory concentration were calculated for each extract and the Significant activity was observed for ethyl acetate extract (E. coli-11.33 mm, S. aeruginosa-16.0 mm) and alcoholic fractions (E. coli-15.33 mm and P. aeruginosa-10.66 mm) for concentration 500 mcg/ml.
Conclusion: Thus, the result in the present experiment ensures the traditional use of M. minuta as antibacterial agent. Further, the most active extracts can be subjected for isolation of the therapeutic antimicrobials and its formulation which will be relatively safer than synthetic medicines and offering profound therapeutic benefits at the more affordable price.
Keywords: M. minuta, Antimicrobial activity, Infectious disease, Traditional drugs.
Infectious diseases, also known as transmissible diseases or communicable diseases comprise clinically evident illness, resulting from the infection, presence and growth of pathogenic biological agents in an individual host organism. Infectious pathogens include some viruses, bacteria, fungi, protozoa, multi cellular parasites, and aberrant proteins known as prions. Worldwide, infectious disease is the number one cause of death accounting for approximately one-half of all deaths in tropical countries [1]. Death from infectious disease, ranked 5th in 1981, had become the 3rd leading cause of death in 1992, an increase of 58%.
There has been remarkable progress in the prevention, control and even eradication of infectious diseases with improved hygiene and development of antimicrobials and vaccines. However, infectious diseases still remain a leading cause of global disease burden with high morbidity and mortality especially in the developing world. Furthermore, there have been threats of new diseases during the past three decades due to the evolution and adaptation of microbes and the re-emergence of old diseases due to the development of antimicrobial resistance and the capacity to spread to new geographic areas [2].
Since antiquity, humans have used plants to treat common infectious diseases and some of these traditional medicines are still included as part of the habitual treatment of various maladies. The isoquinoline alkaloid emetine obtained from the underground part of Cephaelis ipecacuanha, and related species, has been used for many years as an amoebicidal drug as well as for the treatment of abscesses due to the spread of Escherichia histolytica infections. Another important drug of plant origin with a long history of use is quinine. This alkaloid occurs naturally in the bark of Cinchona tree is used as antimalarial drug. It is estimated that today, plant materials are present in, or have provided the models for 50% Western drug. The increasing failure of chemotherapeutics and antibiotic resistance exhibited by pathogenic microbial infectious agents has led to the screening of several traditionally used medicinal plants for their potential antimicrobial activity [3]. Marsilea is a genus of approximately 65 species of aquatic ferns of family marsileaceae and in ayurveda, some of these species are recommended for treatment of psycopathy, diarrhea, cough, bronchitis and skin infections [4]. Hence, in the present study one of the traditionally used, yet not scientifically investigated, species, Marsilea minuta was screened for its antimicrobial activity.
Extraction of whole plant of Marsilea minuta was carried out using solvents of increasing polarity by hot continuous extraction method using soxhlet apparatus. 200 g of shade dried plant were taken and size reduced, extracted with 1L of petroleum ether in the round bottom flask and extraction was continued for 10 hrs. The extract obtained was collected and concentrated. The concentrated extract was then weighed and stored. Then the residue obtained after extraction was packed into the body of the soxhlet and then extracted with chloroform, ethyl acetate and ethanol in the same manner. Each time before extracting with the next solvent, the drug material was dried at room temperature. Each extract was concentrated by distilling off the solvent and then evaporating to dryness.
Finally the marc obtained was packed into a round bottom flask and refluxed with water. The extract obtained was concentrated in vacuum drier to obtain aqueous extract. All the extracts were weighed and stored for further studies [5]. All the extracts were subjected to antibacterial study using well diffusion method. Mueller Hinton Agar Medium (MHA)was used for the study)[6,7]. Dehydrated medium supplied by HI media laboratories Pvt. Ltd., Mumbai were used for well diffusion studies for testing antibacterial activity of the plant extracts. The reconstituted medium has the following composition.
Beef infusion -300 ml, Casein hydrolysate -17.4 gm, starch -10 gm, Agar -10 gm and Distilled water -1000 ml pH -7.4
Four bacterial strains were used to assess the antimicrobial properties of the plant extracts. The isolates were procured from local clinical laboratories and was identified according to guidelines in the Bergey’s Manual of Systematic Bacteriology and by studying their culture, morphological and biochemical properties. Bacterial strains tested were confirmed as Escherichia coli, Streptococcus pneumonia, Pseudomonas aeruginosa and Staphylococcus aureus. The wells were made using a 5 mm cork borer sterilized using flame and alcohol. The bacterial isolates were first grown in a nutrient broth for 18 hrs before use. A sterile swab was dipped into nutrient broth culture and was rotated firmly against upper inside wall of the tube to expel the excess fluid. The entire surface of Mueller Hinton agar medium was lawned with the swab soaked with inoculums. As soon as the MHA was partly solidified, the plates were inverted and left for 2 hrs. When cooled, wells were made on the solidified medium in the plate. 100 μl of the varying concentrations (100, 200, 300, 400 and 500 μg/ml) of the extracts were introduced into the wells with the help of micropipettes.
The plates were incubated over night at 370C. Microbial growth was determined by measuring the diameter of zone of inhibition. For each bacterial strain, controls maintained where DMSO was used instead of the extract. The experiment was done in triplicate and the results obtained by measuring the zone diameter.
The minimum inhibitory concentration of all extracts was found out by graphical method [7]. By successive solvent extraction method, petroleum ether extract (PEE), chloroform extract (CHE), ethyl acetate extract (EAE), alcoholic extract (ALE), and aqueous extract (AQE) of M. minuta were prepared. Antibacterial activity of petroleum ether, chloroform, ethyl acetate, alcohol and aqueous extracts of M. minuta were determined and experiments were done in triplicate and the results were expressed as mean standard deviation. The results obtained were tabulated in the table 1 and the minimum inhibitory concentration obtained for each extract was tabulated in table 2. The photographs of the plates were depicted in the figures 1 and 2.
Table 1: Zone of inhibition obtained for different extracts of M. minuta against four microorganisms
Extracts |
Microorganism |
Zone of inhibition of various extracts (mm) at different concentration |
|||||
100mcg/ ml |
200mcg/ml |
300mcg/ml |
400mcg/ml |
500mcg/ml |
|||
|
|
|
|
|
|||
PEE |
E. coli |
- |
- |
- |
- |
- |
|
|
S. aureus |
- |
- |
- |
- |
- |
|
|
P. aeruginosa |
- |
- |
- |
- |
- |
|
|
S. pneumonia |
- |
- |
- |
- |
- |
|
CHE |
E. coli |
- |
- |
6.33±0.58 |
8.0± 1.0 |
8.66±0.57 |
|
|
S. aureus |
- |
- |
- |
7.66±0.577 |
8.0± 1.0 |
|
|
P. aeruginosa |
- |
- |
6.33±0.58 |
8.66±5.8 |
10.33±0.58 |
|
|
S. pneumonia |
- |
- |
- |
- |
5.33±0.58 |
|
EAE |
E. coli |
- |
7.33±0.58 |
8.33±0.58 |
10.0±1.0 |
11.33±0.58 |
|
|
S. aureus |
8.66±0.5 |
9.66±0.58 |
10.0±1.0 |
13.33±0.58 |
14.33±0.58 |
|
|
P. aeruginosa |
8±1.0 |
8.66±0.58 |
11.0±1.0 |
13.33±0.58 |
16.0±1.0 |
|
|
S. pneumonia |
7.33±0.5 |
8±1.0 |
10.66±0.5 |
13.66±0.5 |
17.66±0.58 |
|
ALC |
E. coli |
- |
6.33±0.58 |
9.0±1.0 |
12.33±0.58 |
15.33±0.57 |
|
|
S. aureus |
- |
6.33±0.57 |
7.66±0.58 |
9.66±0.57 |
12.33±0.58 |
|
|
P. aeruginosa |
- |
5.66±0.58 |
8±1.0 |
9.33±0.58 |
10.66±0.58 |
|
|
S. pneumonia |
- |
- |
6.66±0.58 |
8.33±0.58 |
10±1.00 |
|
AQE |
E. coli |
6.66±0.5 |
9±1.0 |
9.66±0.58 |
11.66±0.58 |
12±1.00 |
|
|
S. aureus |
8±1.0 |
- |
8±1.00 |
9.33±0.58 |
10.00±0.58 |
|
|
P. aeruginosa |
- |
- |
- |
6.66±0.58 |
8.66±0.50 |
|
|
S. pneumonia |
- |
- |
- |
- |
6.0± 1.0 |
|
STD |
Zone of |
inhibition of standard (mm) at different concentration |
|||||
|
Microorganism |
5mcg/ml |
10 mcg/ml |
20 mcg/ml |
40 mcg/ml |
80 mcg/ml |
|
Stre- |
E. coli |
- |
- |
7.00±1.00 |
7.66±0.58 |
9.00±0.57 |
|
pto- |
|
|
|
|
|
|
|
S. aureus |
6.33±0.5 |
7±1.00 |
7.66±0.57 |
8.66±0.57 |
9.66±0.58 |
||
myc- |
|||||||
in |
P. aeruginosa |
7 |
6.66±0.58 |
7.00±1.00 |
8.33±0.58 |
9.33±0.58 |
|
|
S. pneumonia |
- |
- |
7.33±0.58 |
8.66±0.57 |
9.00±1.00 |
|
Values |
are expressed as |
mean±S. D; n=3 |
|
|
|
||
Table 2: Minimum inhibitory concentration obtained for each extract against four microorganisms.
Micro organism |
MIC (mcg/ml) |
||||||
PEE |
CHE |
EAE |
ALC |
AQE |
STD |
||
E. coli |
>500 |
275.8 |
185.3 |
141.6 |
94.19 |
14.10 |
|
S. aureus |
>500 |
≤400 |
97.94 |
142.3 |
223.7 |
5.22 |
|
P. aeruginosa |
>500 |
295.3 |
92.3 |
136.87 |
≤ 400 |
8.69 |
|
S. Pneumonia |
>500 |
≤500 |
136.6 |
289.26 |
≤ 400 |
19.85 |
|
All the extracts showed activity towards the tested microorganisms except petroleum ether extract. Ethyl acetate extract was more active towards S. aureus and P. aeruginosa. Alcohol and chloroform extract was active toward E. coli and P. aeruginosa. Aqueous extract was active against E. coli and S. aureus.
The ethyl acetate extract was most potent against the tested organisms with an MIC range of 90-190 mcg/ml. The lowest MIC (highest potency) exhibited was 92.3mcg/ml against S. aureus. Ethyl acetate and alcoholic extracts showed good response on both gram-positive and gram negative bacteria. Although Gram negative bacteria tend to have higher intrinsic resistance to most antimicrobial agents, in spite of this, impressive activity was observed for ethyl acetate extract (E. coli-11.33 mm, S. aeruginosa-16.0 mm) and alcoholic fractions (E. coli-15.33 mm and P. aeruginosa-10.66 mm) for concentration 500 mcg/ml.
The ethyl acetate extract was found to be active against S. aureus and P. aeruginosa which are the causative organisms for skin infections; therefore this activity can be a scientific proof for the traditional use of the plant [8,9]. The plant extracts were also found to be active against S. pnuemonia which cause respiratory tract infections, thus providing a scientific basis for the use of plant paste in cough and respiratory infections.
(1-Chloroform extract, 2- Ethyl acetate extract, 3- Alcoholic extract, 4-Aqueous extract. All extracts were taken in concentration 500 mcg/ml)
Fig. 1: Anti microbial activity obtained for different extracts against E. coli (left) and S. aureus (right)

Fig. 2: Anti microbial activity obtained for different extracts against S. pneumonia (left) and P. aeruginosa (right)
The increasing failure of chemotherapeutics and antibiotic resistance exhibited by pathogenic microbial infectious agents has led to the screening of several traditionally used medicinal plants for their potential antimicrobial activityas they will be safer, effective and cheap [3,10,11]. Thus, the result in the present experiment also ensures the traditional usage of M. minuta as antibacterial agent.
Further, the most active extracts can be subjected for isolation of the therapeutic antimicrobials and its formulation which will be relatively safer than synthetic medicines and offering profound therapeutic benefits at the more affordable price.
REFERENCES